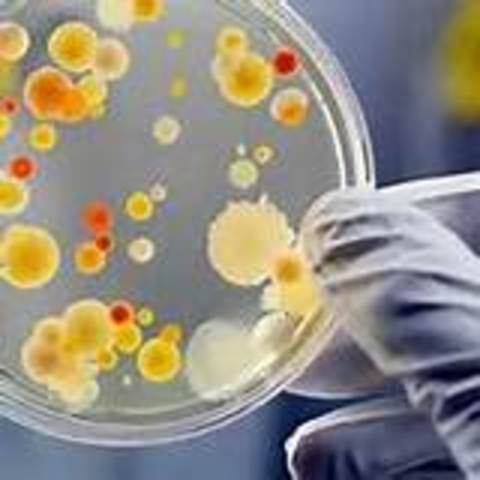
APARICION DE LA MICROBIOLOGIA

-
-
A partir de la mitad del siglo XIX, el número de hospitales creció mucho, debido sobre todo al descubrimiento de la anestesia y de las técnicas quirúrgicas asépticas. Durante el siglo XX la demanda de hospitales ha aumentado a la par que el progreso.
Los primeros hospitales agrupaban a todos los pacientes en una única sala, con independencia de su enfermedad. Excepciones notables eran los asilos mentales, los centros de cuarentena y los sanatorios para tuberculosos que se establecieron a finales -
a finales del siglo XIX, la enfermera adquiere una posición social asumiendo la atención a enfermos y necesitados, pero ellas aún continúan su labor dirigida a los pobres y abandonados, basando su práctica en los valores morales y religiosos de la mujer consagrada, desplegando toda su capacidad de entrega y servicio. Hasta la llegada de la primera representante de la profesión: Florence Nightingale (1820 -1910), se inicia el reconocimiento por su valor intelectual y progresivamente
-
http://www.librosmaravillosos.com/mdenespanol/florencianightingale.html partir del proyecto de Florence Nightingale en el siglo XIX, se hizo necesario reglamentar el entrenamiento personal y el control social del ejercicio, dadas las condiciones que hasta el momento marcaron ésta práctica y los antecedentes del desarrollo histórico que identifican la labor de enfermería.Además porque Florence Nightingale, se oponía al pensamiento médico que hasta entonces no consideraba necesario preparar el personal de enfermería. en 1860 desarrollo su toeria del entorno
-
fueron fundadas en 1822 en ciudades comosanta marta y boyaca
-
Louis Pasteur (1822-1895), considerado el padre de la Microbiología Médica, y Robert Koch (1843-1910) fueron contemporáneos de Cohn. Quizá el mayor logro de Pasteur consistió en la refutación mediante cuidadosos experimentos de la por aquel entonces muy respetada teoría de la generación espontánea, lo cual permitió establecer firmemente a la microbiología dentro de las ciencias biológicas. Pasteur también diseñó métodos para la conservación de los alimentos (pasteurización) y vacunas
-
se inicio una enfermería enseñada por principios,donde se tenia en cuenta el libro del arte deenfermería escrito por los hermanos de la OrdenSAN JUAN DE DIOS en el año 1833, cuyo fin fueinstruir a las enfermeras de esta orden a cuidara los enfermos.Los contenidos de esta obra, entre otros,describen la forma de administrar la alimentacióna los enfermos, aplicación de los medicamentosprescritos, la realización del aseo y consuelo del espiritu
-
los cambios en la atención médica y en los hospitales durante las guerras del siglo XIX, donde el aumento enfermos y heridos superó la capacidad de atención posible para la época, obligando a una reorganización hospitalaria; así como el acceso de la mujer a la formación universitaria, todo lo cual se refleja en la formación y ejercicio de la profesión para nuestra actual época.
-
En lo referente a la enfermeria resurgen las antiguas diaconisas (cuyo origen data de los primeros años de la era cristiana),pero en este caso son diaconisas protestantes (año 1836). Asi mismo,el pastor luterano teodoro fiedner (1800-1864) funada en alemania el instituto de diaconisas de kaiserswerth.
-
Era el recinto donde dormian los enfermos que seria visitados en el sueño por el dios.
-
A partir de entonces prepara la creación de una escuela para entrenamiento de enfermeras seglares, con disciplinas similares a las militares, por la vigilancia continua del personal, el uso de uniformes y los aspectos relacionados con el orden, las jerarquías y el saber entre otras características, para ofrecer la mayor utilidad del servicio. El entrenamiento en aspectos morales más que éticos se limitaba a la prohibición y represión del comportamiento sexual, no sobre los principios basicos
-
Ethel Gordón Fenwick, estableció estándares de entrenamiento, uspiciados por la institución con la modalidad preestablecida por Nightingale, donde se integraba una formación didáctica y sistematizada. Preparó enfermeras para la atención domiciliaria.
-
Notas sobre Enfermería”, trata sobre el cuidado de los enfermos y la función social de la enfermera y critica la concepción que se tenía de la enfermera, respecto a su sumisión y servicio. Define la Enfermería como el arte de mantener el estado de salud, y de prevenir la enfermedad o recuperarse de ella e Identifica la necesidad de preparar el personal para dar atención adecuada y especializada.
-
florence Nightingale en 1860, organiza la creación y puesta en marcha de su Escuela Preparatoria para Enfermeras, con el apoyo institucional del Hospital Santo Tomás de Londres, su objetivo primordial formar enfermeras capaces de adiestrar a otras y de ocupar puestos en los hospitales e instituciones públicas con un modelo
-
El Movimiento Internacional de la Cruz Roja y de la Media Luna Roja, más conocido internacionalmente como Cruz Roja, y en algunos países musulmanes como Media Luna Roja, es un movimiento humanitario mundial de características particulares y única en su género, por su relación particular con base en convenios internacionales con los estados y organismos internacionales por un fin netamente humanitario.
-
El símbolo de la Cruz Roja sobre un fondo blanco fue adoptado oficialmente en la Primera Convención de Ginebra El emblema ya fue decidido el 28 de octubre de 1863 en la Conferencia Internacional preparatoria de la Convención de Ginebra. El emblema inicialmente propuesto como distintivo internacional era "un brazal blanco en el brazo izquierdo" sin incluir ningún símbolo (la bandera blanca era y es universalmente utilizada como símbolo de alto el fuego),
-
En 1867 se establece “un curso especial teórico – práctico para comadronas y Parteras” en el Hospital San Juan de Dios de Bogotá, dictado por un profesor de la Universidad Nacional de Colombia y el Jefe de la Clínica del Servicio. El código civil de 1887 consagra como trabajos específicamente femeninos los de Directora de Colegio, Maestra de Escuela, Obstetriz, Posadera y Nodriza. En 1905 cuando se reglamenta la profesión de medicina, se establece que: “Podrán ejercer como comadronas
-
fue la primera organizacion profesional de enfermeras como defensa a la dominación y dependencia masculina del rol que solamente ejercían las mujeres y como gestora de la defensa de la profesión misma, ante la oposición de las mujeres que no aceptaban la necesidad de formación estandarizada, entre ellas Florence Nightingale, para quien la experiencia práctica y las cualidades morales eran elementos esenciales para una enfermera.
-
consejo de matronas de gran bretaña. las matronas son las personas que se encargan del cuidado de la salud de las mujeres durante del embarazo.
-
estaba dirijido por enfermeras que trabajaban para asegurar la calidad de la atencion de enfermeria para todos
-
se evidenció la importancia de que ya existiera personal preparado y de la organización hospitalaria, se intensificó la necesidad de servicios de enfermería, su expansión, creación y fianzamiento de identidad, fortalecimiento del conocimiento para el desarrollo de actividades que requerían mayor cuidado, como consecuencia de las guerras. Finalmente, en 1919 el parlamento Inglés aceptó la aplicación del Registro estatal para enfermeras
-
La muestra llamada Tres escuelas una historia. Legado de la Universidad Nacional de Colombia a la enfermería del país, y presentada en el Claustro de San Agustín, se orientó a reconstruir el génesis y el desarrollo de la enseñanza de la Enfermería en la UN desde 1920 hasta 1957: la Escuela de Comadronas y Enfermeras (1920-1937), la Escuela Nacional de Enfermeras (1937-1944) y la Escuela Nacional Superior de Enfermeras (1944-1957).
-
se adquiere avance en el ejercicio social y público de la profesión que desde siempre se desempeño de manera informal y devaluada, aunque se desarrolla en el ámbito hospitalario y en torno siempre a las acciones médicas y que fue reconocido oficialmente en 1922, a diferencia de la enfermera que continúa su labor de servicio a la comunidad, donde es ella la que identifica los riesgos psicosociales y ambientales, realiza los controles básicos de la salud y se convierte en la asistente
-
1924 se estableció en la facultad de medicina de la U. nacional una escuela para la enseñanza de comadronas y enfermeras.
-
El emblema de la Media Luna Roja fue utilizado por primera vez en el conflicto armado ruso-turco entre el Imperio Otomano y Rusia (1877-1878), debido a que el Imperio Otomano, aunque respetaba el símbolo de la Cruz Roja, consideraba que hería las susceptibilidades del soldado musulmán.3 El símbolo era oficialmente adoptado en 1929 y hasta el momento 33 estados Islámicos lo han reconocido.
-
1929 escuela nacional de enfermeros fundada por el gobierno nacional.
-
1931 escuela nacional de enfermeras visitadoras creada por el departamento nacional de higiene y asistencia publica
-
en este año fue reconocida su labor.
-
Exitian las tabillas o iamata, que atestiguaban las curas milagrosas.
-
Los tholos eran los que cotenian agua para la purificacion,que generalmente llegaba de una limpia vertiente de los alrededores.
A list shows items. A timeline shows sequence.
Use Timetoast to make dates, milestones, and turning points easier to understand in a clear visual format. Timetoast is a timeline maker for work, school, research, and stories.